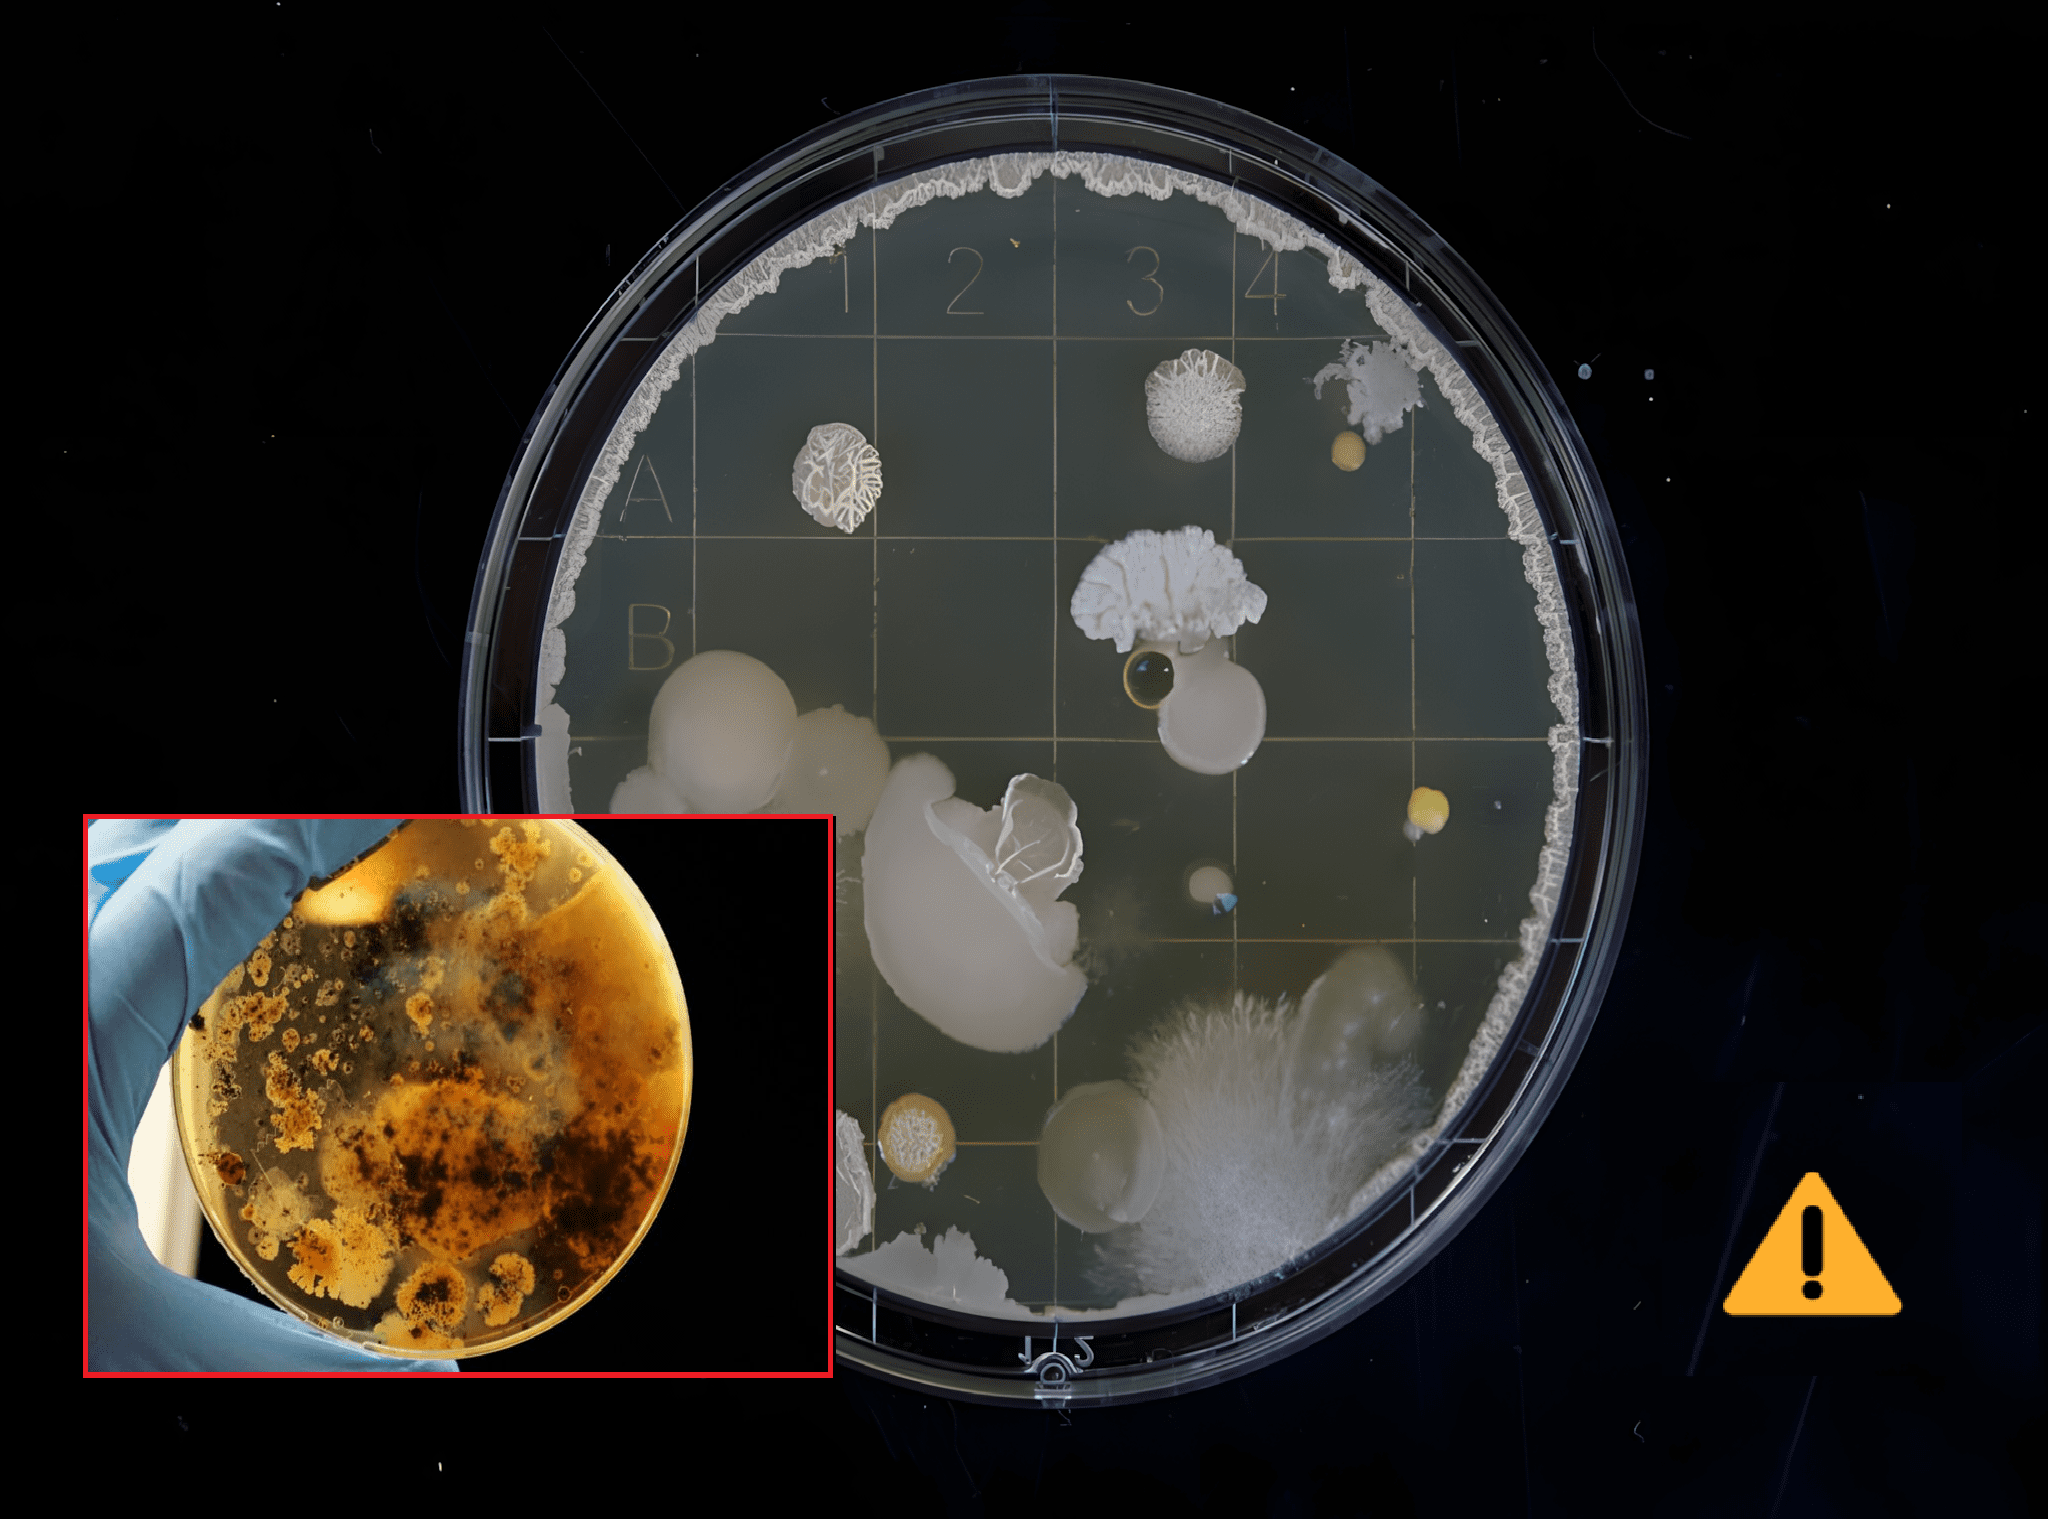

Wetenschappers van gerenommeerde universiteiten zoals Stanford, Yale, MIT en Cambridge slaan alarm over een nieuwe ontwikkeling in de wereld van synthetische biologie: zogeheten ‘spiegelleven’. Deze kunstmatige bacteriën, opgebouwd uit moleculen die de omgekeerde structuur hebben van alles wat in de natuur voorkomt, zouden een ramp kunnen veroorzaken van ongekende proporties. Volgens een nieuw rapport in het wetenschappelijke tijdschrift Science vormt spiegelleven een serieus gevaar voor het voortbestaan van het leven op aarde.
Maar wat is spiegelleven precies?
Spiegelleven verwijst naar synthetisch gecreëerde organismen die zijn opgebouwd uit moleculen die het spiegelbeeld zijn van de natuurlijke bouwstenen van het leven. Normaal gesproken zijn DNA en eiwitten opgebouwd uit zogeheten ‘linksdraaiende’ of ‘rechtsdraaiende’ moleculen. Bij spiegelleven worden deze omgedraaid. Het resultaat is een compleet nieuw type micro-organisme dat het menselijk lichaam – en dat van dieren en planten – simpelweg niet herkent.
En juist daarin schuilt het gevaar.
Doordat deze bacteriën een volledig andere moleculaire opbouw hebben dan alles wat in de natuur voorkomt, kunnen ze ongemerkt het lichaam binnendringen. Ons immuunsysteem is er niet op gebouwd om deze indringers te detecteren, laat staan te bestrijden. Mocht een dergelijk organisme ooit per ongeluk uit een laboratorium ontsnappen, dan zouden we geen idee hebben hoe het te stoppen. Geen afweer, geen diagnose, geen behandeling – en dus ook geen controle.